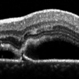
RPE Micro Rip in Central Serous Chorioretinopathy RPE Micro Rip in Central Serous Chorioretinopathy

-
By Nichole Lewis
Retinal Consultants of Sacramento - Uploaded on Nov 20, 2017.
- Last modified by Caroline Bozell on Nov 21, 2017.
- Rating
- Appears in
- Retinal Images
- Condition/keywords
- retinal macroaneurysm, focal laser
- Photographer
- Nichole Lewis
- Imaging device
- Fundus camera
- Description
- Repaired retinal macroaneurysm with focal laser.


 Initializing download.
Initializing download.